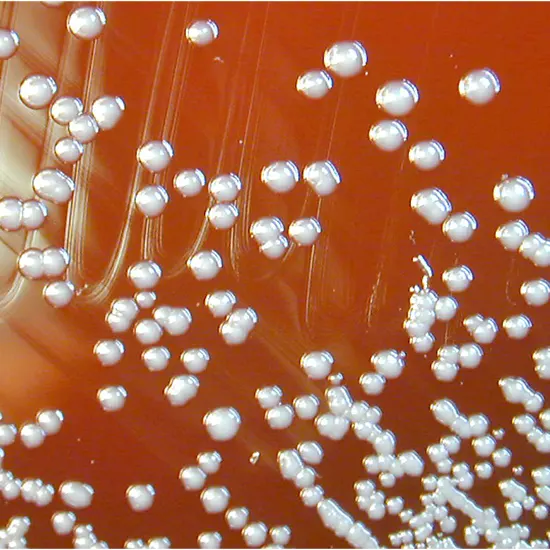

An increasingly well-known cause of nosocomial pneumonia, particularly in immunocompromised children, is Burkholderia cepacia. The organism was first identified as the source of "soft rot" in onions in 1950.
An increasingly well-known cause of nosocomial pneumonia, particularly in immunocompromised children, is Burkholderia cepacia. The organism was first identified as the source of "soft rot" in onions in 1950. It shares a close relationship with the plant pathogens Pseudomonas mallei, Pseudomonas pseudomallei, Pseudomonas pickettii, and other Pseudomonas species.
The organism is widespread and adaptable; it tends to flourish in challenging environments and can even use penicillin as a food source. The organism is hardy and immune to most antiseptics, disinfectants, and preservatives. The pathogen is believed to be contracted by children in hospitals or through contact with colonised siblings. These days, it's possible to identify strain-specific traits that, in part, dictate which strains are effective colonisers of sensitive people, like those with cystic fibrosis (CF).
Once they invade the lungs, Burkholderia bacteria are challenging to treat because they frequently develop resistance to several medications. Some species, though, may respond well to antibiotic cocktail treatments.
What is Burkholderia cepacia infection?
Burkholderia cepacia, or B. cepacia, is a crew of microorganisms observed in soil and water. It can cause serious respiratory infections in patients who are susceptible to illness. Several non-respiratory B. cepacia outbreaks have been linked to contaminated scientific products.
Burkholderia cepacia is a kind of microorganism that can motivate infections in human beings with weakened immune structures or underlying clinical prerequisites such as cystic fibrosis. Burkholderia cepacia infection, additionally acknowledged as B. cepacia contamination or cepacia syndrome, can lead to a variety of signs and symptoms.
In some cases, the contamination can also no longer cause any symptoms, whilst in others it can cause pneumonia, bloodstream infections, pores and skin and tender tissue infections, and urinary tract infections.
Epidemiological facts of B.cepacia
Although B. cepacia complex strains are routinely recovered from the environment, human infections are rarely linked to widespread environmental species.
B. cepacia complex, which has historically been thought of as a low pathogenic organism, can spread from person to person in both healthcare and non-healthcare settings through droplet spread and direct and indirect contact with infectious secretions.
B. cepacia complex can survive for a long time in water or disinfectants.
According to the U.S. Cystic Fibrosis Foundation’s 2012 National Patient Registry, 2.6 per cent of all folks with cystic fibrosis have been contaminated with B. cepacia complicated in contrast to 3.1% in 2005.
The occurrence will increase with age and varies extensively between cystic fibrosis centres. In the United States, B. multivorans and B. cenocepacia account for ~70% of affected person isolates, and the incidence of new contamination with B. multivorans relative to B. cenocepacia has multiplied in recent years.
In comparison, in Canada and some European countries, B. cenocepacia is the predominant species. Molecular typing and epidemiologic investigations guide the person-to-person transmission of B. cepacia complicated at some point of hospitalisation, whilst attending ambulatory clinics, and in the course of social gatherings.
Transmission is facilitated by way of extended shut contact between cystic fibrosis patients, sharing of gear and non-public care items, and through bacterial virulence factors.
What is the Pathophysiology of B cepacia?
B cepacia almost usually is a colonizing organism as a substitute than an infecting organism, however, it might also be vital when remoted from physique fluids that are broadly speaking sterile. The pathophysiology of B cepacia contamination mirrors that of different non-fermentative cardio gram-negative bacilli.
Here are the Other species of Burkholderia cepacia
Burkholderia cepacia is a complex of various intently associated species inside the genus Burkholderia. Some of the different species inside this complicated include:
Burkholderia cenocepacia
This species is closely related to Burkholderia cepacia and is additionally recognized to cause infections in humans with cystic fibrosis.
Burkholderia multivorans
This species is some other member of the Burkholderia cepacia complicated and is oftentimes observed in soil and water. It is additionally acknowledged to cause infections in human beings with cystic fibrosis.
Burkholderia contaminants
This species is intently associated with Burkholderia cepacia and has been removed from a range of environmental sources, together with soil, water, and health centre environments.
Burkholderia vietnamiensis
This species is discovered in soil and water and is recognised to have a symbiotic relationship with plants. It has additionally been removed from cystic fibrosis patients, though it is much less usually related to infections than Burkholderia cepacia and Burkholderia cenocepacia.
Burkholderia dolosa
This species is intently associated with Burkholderia cenocepacia and is additionally recognised to reason infections in human beings with cystic fibrosis. It is essential to notice that whilst these species are intently related, they can fluctuate in phrases of their scientific value and pathogenicity.
Signs and Symptoms of B. cepacia
Burkholderia cepacia is a kind of microorganism that can cause infections in humans with weakened immune systems, cystic fibrosis, or different continual lung diseases.
Symptoms of contamination with Burkholderia cepacia can range relying on the kind and severity of the infection, however, some frequent symptoms and signs and symptoms might also include:
- Fever
- Chills
- Cough
- Shortness of breath
- Chest pain
- Fatigue
- Loss of appetite
- Weight loss
- Muscle aches and joint pain
- Skin rash or infection sepsis (infection of the bloodstream
Causes and Transmission of B.Cepacia
B cepacia is a non-fermentative, aerobic, gram-negative bacillus previously labelled as Pseudomonas. Unlike Pseudomonas aeruginosa, B cepacia is an organism of low virulence with a restricted capacity to motivate contamination in humans.
- Personnel - Hands, antiseptic soaps, hand lotion.
- Respiratory gear
- Respirator tubing condensate, ultrasonic nebulizers, inhalation medications
- Intravenous strains and/or fluids Intravenous solutions, central venous catheters.
- Pressure-monitoring units.
- Pressure transducer fluidsUrine and/or fluids - Indwelling urinary catheters, durometers, irrigation options.
Transmission
It is now not usually recognized how humans with CF end up contaminated with B. cepacia complex. Research has proven that humans with CF can get B. cepacia from others who are contaminated with these bacteria.
The germs unfold both using direct contact, such as kissing, or not directly from touching objects with the germs, such as doorknobs.
This is recognized as cross-infection and can show up in social settings like events, gatherings or meetings. In some cases, shared contamination was once no longer observed in the lungs of an individual with CF till two years after being uncovered to anyone else who used to be contaminated with the germ.
For many humans with CF, contamination with B. cepacia complicated can't be traced again to publicity to every other contaminated person. In these cases, contamination may additionally have passed off by way of publicity to Burkholderia in the herbal surroundings.
It can additionally be unfolded via person-to-person contact, contact with contaminated surfaces and publicity of B. cepacia in the environment.
What are the Risk Factors?
B. cepacia commonly no longer causes sickness in healthful people. However, people with weakened immune structures or persistent lung diseases, in particular cystic fibrosis, might also be greater probable to end up ill with B. an infection. The bacteria is additionally a recognized reason for contamination in hospitalised patients.
Clinical assessment of B.cepacia
Diagnosis of Burkholderia cepacia contamination normally entails an aggregate of medical evaluation, laboratory testing, and imaging studies.
Clinical evaluation
Doctors may additionally suspect Burkholderia cepacia contamination in human beings with signs and symptoms such as fever, cough, shortness of breath, and chest pain, in particular, if they have a record of lung ailment or different chance factors.
Laboratory testing
A definitive prognosis of Burkholderia cepacia contamination requires laboratory testing, which can also include:
Culture: Samples of blood, sputum, or different bodily fluids can be cultured to pick out the presence of Burkholderia cepacia bacteria.
Polymerase chain response (PCR)
PCR assessments can notice the genetic tissue of Burkholderia cepacia microorganisms in samples from patients, such as blood or sputum.
Antibiotic susceptibility testing
Bacteria can be grown in the laboratory and examined for their susceptibility to one of the antibiotics. This helps decide choices for treatment
Management of the Burkholderia cepacia
Treatment for Burkholderia cepacia infections normally includes antibiotics, however, it can be difficult as this microorganism can be resistant to many antibiotics. Here are some normal tips for treating Burkholderia cepacia infections:
Antibiotic therapy
Treatment with antibiotics is commonly the first line of protection in opposition to Burkholderia cepacia infections. However, due to the fact, these microorganisms are frequently resistant to more than one antibiotic, deciding on the proper antibiotic can be challenging. In many cases, a mixture of antibiotics may also be essential to successfully dealing with the infection. Your health practitioner will decide on the antibiotics based totally on the kind of Burkholderia cepacia contamination and the sensitivity of the microorganism to exceptional antibiotics.
Supportive care
In addition to antibiotics, supportive care is regularly wished to manipulate the signs of Burkholderia cepacia infections. This may additionally consist of oxygen therapy, bronchodilators, and different medicines to assist ease respiratory difficulties. If the contamination has unfolded to different components of the body, such as the blood or organs, extra therapy might also be necessary.
Lung transplantation
In some cases, Burkholderia cepacia infections can lead to massive lung damage, which may also require a lung transplant. However, because microorganisms are tough to eradicate from the lungs, lung transplantation can also no longer usually be possible.
In general, infections prompted by Burkholderia cepacia can be challenging to deal with and can have a terrible prognosis in persons with cystic fibrosis. This is due to the fact the organisms are resistant to many antibiotics, and the contamination can lead to a decline in lung characteristics and standard health.









